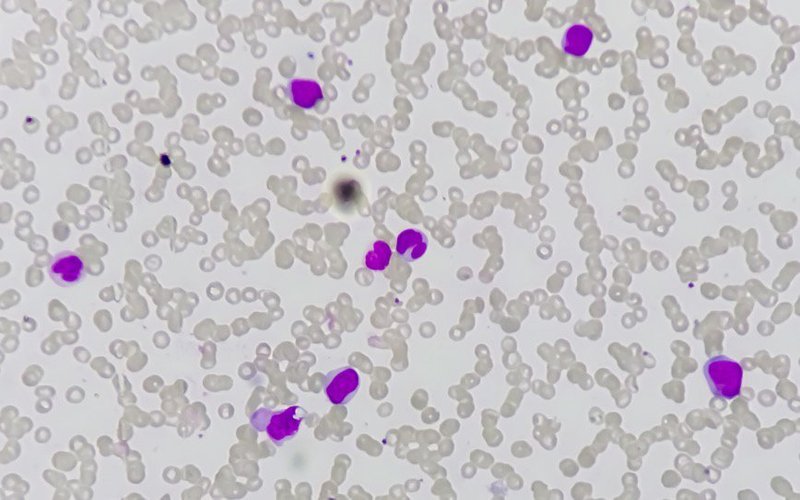
Chimeric Therapeutics to supply CHM 0201 for cell study into treatments for acute myeloid leukaemia

Cell therapy specialist Chimeric Therapeutics (ASX: CHM) has entered into an agreement with The University of Texas MD Anderson Cancer Center to support the ADVENT-AML Phase 1B study, in which its off-the-shelf universal donor NK cell therapy CHM 0201 will be evaluated alongside the standard of care treatment for patients with newly-diagnosed acute myeloid leukaemia (AML).
Under the terms of the agreement, Chimeric will provide CHM 0201 for the purposes of the study as well as partial financial support.
Additional grant funding will come from multiple sources including the US non-profit organisation Gateway for Cancer Research.
Newly-diagnosed subjects
The study will enrol up to 20 subjects with newly-diagnosed AML who are not eligible for intensive chemotherapy or allogeneic stem cell transplants.
Recruitment will follow completion of a dose confirmation cohort assessing the safety of the novel combination treatment in subjects with relapsed or refractory AML.
It will be the first trial to evaluate the synergy of NK cell therapy in combination with current standard of care, Azacitidine with Venetoclax (AZA-VEN).
As the trial progresses beyond dose confirmation, it will also become the first of its kind to evaluate cellular therapy in new AML patients.
The study has received IND (investigational new drug) clearance by the US Food and Drug Administration (FDA) and is expected to commence recruiting participants by year end.
Emerging evidence
Chimeric chief medical officer said the company was keen to work with MD Anderson.
“This exciting new trial aligns with emerging evidence that cell therapies provide the best clinical outcomes in the earliest line of treatment,” he said.
“By combining CHM 0201 with current standard of care, we may be able to significantly enhance the outcomes for AML patients.”
Most common leukemia
AML is the most common acute leukaemia in adults with a median age at diagnosis between 65 years and 72 years.
Despite treatment advances, patients who are not eligible for intensive chemotherapy or allogeneic stem cell transplant have limited therapeutic options.
Outcomes for these high-risk subgroups are reported to be poor, with median overall survival of up to nine months in the newly-diagnosed setting and 2.4 months for patients with relapse or refractory disease.
Novel therapies have been considered urgent in order to improve health outcomes for patients with AML.